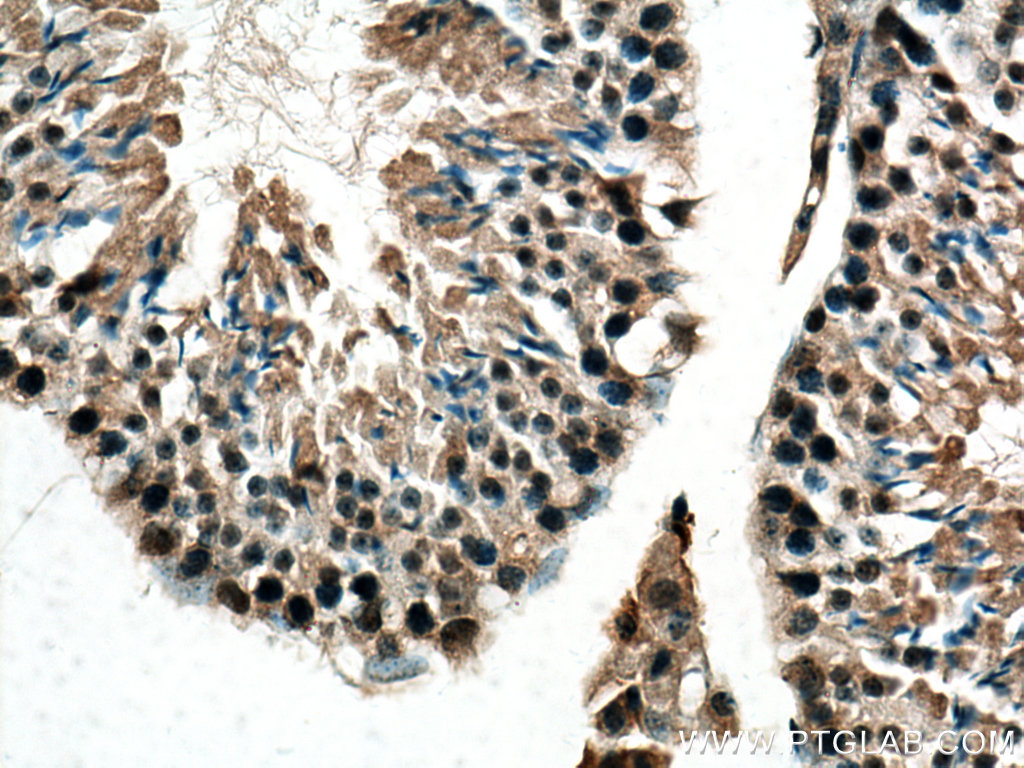

验证数据展示
经过测试的应用
| Positive WB detected in | HeLa cells, MCF-7 cells |
| Positive IHC detected in | mouse testis tissue, human kidney tissue Note: suggested antigen retrieval with TE buffer pH 9.0; (*) Alternatively, antigen retrieval may be performed with citrate buffer pH 6.0 |
| Positive IF/ICC detected in | HeLa cells |
推荐稀释比
| 应用 | 推荐稀释比 |
|---|---|
| Western Blot (WB) | WB : 1:1000-1:4000 |
| Immunohistochemistry (IHC) | IHC : 1:50-1:500 |
| Immunofluorescence (IF)/ICC | IF/ICC : 1:50-1:500 |
| It is recommended that this reagent should be titrated in each testing system to obtain optimal results. | |
| Sample-dependent, Check data in validation data gallery. | |
发表文章中的应用
| WB | See 2 publications below |
产品信息
28534-1-AP targets DNA-PKcs in WB, IHC, IF/ICC, ELISA applications and shows reactivity with human, mouse samples.
| 经测试应用 | WB, IHC, IF/ICC, ELISA Application Description |
| 文献引用应用 | WB |
| 经测试反应性 | human, mouse |
| 文献引用反应性 | human |
| 免疫原 |
CatNo: Ag29100 Product name: Recombinant human PRKDC protein Source: e coli.-derived, PGEX-4T Tag: GST Domain: 3979-4128 aa of NM_006904 Sequence: LMYSIMVHALRAFRSDPGLLTNTMDVFVKEPSFDWKNFEQKMLKKGGSWIQEINVAEKNWYPRQKICYAKRKLAGANPAVITCDELLLGHEKAPAFRDYVAVARGSKDHNIRAQEPESGLSEETQVKCLMDQATDPNILGRTWEGWEPWM 种属同源性预测 |
| 宿主/亚型 | Rabbit / IgG |
| 抗体类别 | Polyclonal |
| 产品类型 | Antibody |
| 全称 | protein kinase, DNA-activated, catalytic polypeptide |
| 别名 | DNAPK, DNPK1, PRKDC, DNA-PK catalytic subunit, DNA-dependent protein kinase catalytic subunit |
| 计算分子量 | 469 kDa |
| 观测分子量 | 350-460 kDa |
| GenBank蛋白编号 | NM_006904 |
| 基因名称 | PRKDC |
| Gene ID (NCBI) | 5591 |
| RRID | AB_2881165 |
| 偶联类型 | Unconjugated |
| 形式 | Liquid |
| 纯化方式 | Antigen affinity purification |
| UNIPROT ID | P78527 |
| 储存缓冲液 | PBS with 0.02% sodium azide and 50% glycerol, pH 7.3. |
| 储存条件 | Store at -20°C. Stable for one year after shipment. Aliquoting is unnecessary for -20oC storage. |
背景介绍
PRKDC, also named as HYRC, HYRC1, DNPK1 and p460, belongs to the PI3/PI4-kinase family. PRKDC is a serine/threonine-protein kinase that acts as a molecular sensor for DNA damage. Involved in DNA nonhomologous end joining (NHEJ), PRKDC is required for double-strand break (DSB) repair and V(D)J recombination. PRKDC must be bound to DNA to express its catalytic properties. It promotes processing of hairpin DNA structures in V(D)J recombination by activation of the hairpin endonuclease artemis (DCLRE1C). It is required to protect and align broken ends of DNA. PRKDC may also act as a scaffold protein to aid the localization of DNA repair proteins to the site of damage. It is found at the ends of chromosomes, suggesting a further role in the maintenance of telomeric stability and the prevention of chromosomal end fusion. It also involved in modulation of transcription. It recognizes the substrate consensus sequence [ST]-Q. PRKDC phosphorylates 'Ser-139' of histone variant H2AX/H2AFX, thereby regulating DNA damage response mechanism. It phosphorylates DCLRE1C, c-Abl/ABL1, histone H1, HSPCA, c-jun/JUN, p53/TP53, PARP1, POU2F1, DHX9, SRF, XRCC1, XRCC1, XRCC4, XRCC5, XRCC6, WRN, c-myc/MYC and RFA2. The antibody recognizes the C-term of PRKDC.
实验方案
| Product Specific Protocols | |
|---|---|
| IF protocol for DNA-PKcs antibody 28534-1-AP | Download protocol |
| IHC protocol for DNA-PKcs antibody 28534-1-AP | Download protocol |
| WB protocol for DNA-PKcs antibody 28534-1-AP | Download protocol |
| Standard Protocols | |
|---|---|
| Click here to view our Standard Protocols |
发表文章
| Species | Application | Title |
|---|---|---|
Sci Adv SMYD2 inhibition-mediated hypomethylation of Ku70 contributes to impaired nonhomologous end joining repair and antitumor immunity | ||
Exp Hematol Peposertib suppresses generation of FLT3-internal tandem duplication formed by contralateral double nicks |